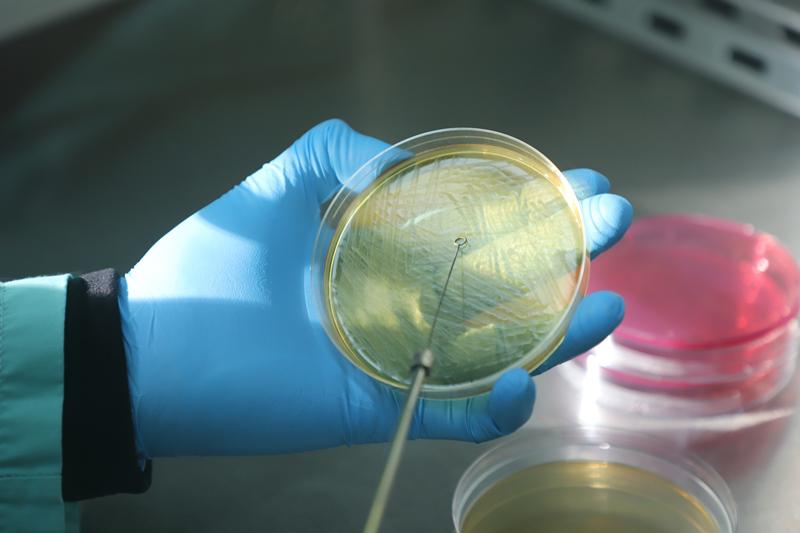
vacuna 1

Mariel Tschieder fue reelecta al frente de la Federación Argentina de Colegios de Abogados
La abogada rafaelina continúa haciendo historia tras ser la primera mujer en presidir la FACA en sus 104 años de existencia. Ahora va por su segundo mandato en una institución que agrupa a más de 80 colegios y asociaciones.